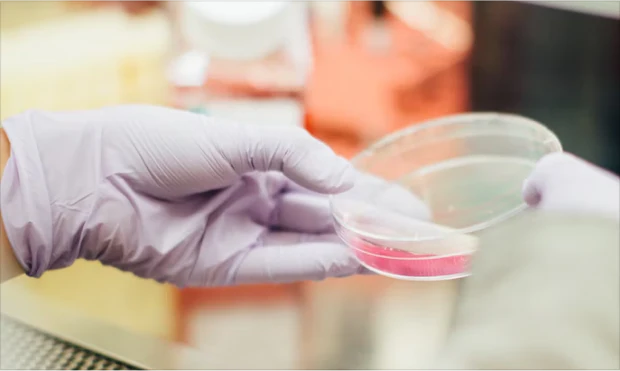

Berberine HCL 98% - 60 Tablets
Berberine HCL 98% - 60 Tablets
Product Information
Miduty’s Berberine 98% is a plant-based formulation that combines berberine (98% strength) with bitter melon fruit extract (15:1), chromium picolinate, gymnema sylvestre, and vitamin B12.
These ingredients have been studied for their potential roles in supporting normal carbohydrate metabolism, maintaining blood glucose levels within the normal range, and contributing to general wellbeing. Vitamin B12 also contributes to normal energy-yielding metabolism and the reduction of tiredness and fatigue.
This supplement is intended to be used as part of a balanced diet and healthy lifestyle. Individual responses may vary. For personalised advice, consult a qualified healthcare professional.
( incl. of customs duties)
10% Discount on even quantities of the same item (e.g., 2, 4, 6, etc.).
Share
Couldn't load pickup availability









Miduty Berberine 98% – Part of a Balanced Lifestyle
High blood sugar is a growing concern, often linked to lifestyle, diet, and genetics. Because it can develop without clear symptoms, regular monitoring and healthy habits are important.
Miduty’s Berberine HCL 98% combines berberine with kidney bean, bitter melon, gymnema, chromium, and vitamin B12. These ingredients have been studied for their potential to support normal carbohydrate metabolism and help maintain blood glucose within the normal range. Vitamin B12 also contributes to normal energy metabolism and helps reduce tiredness and fatigue.
This supplement is intended for adults as part of a balanced diet and healthy lifestyle. For personalised advice, consult a healthcare professional.

Scientific/Clinical Studies
[1] https://www.ncbi.nlm.nih.gov/pmc/articles/PMC4027280/
[2] https://www.ncbi.nlm.nih.gov/pmc/articles/PMC2410097/
[3] https://pubmed.ncbi.nlm.nih.gov/15208835/
[4] https://www.ncbi.nlm.nih.gov/pmc/articles/PMC3649932/
[5] https://www.researchgate.net/publication/308578091_Vitamin_B12_Deficiency_and_Metformin_Use
-
What’s it for?
-
Description
-
Clinical Studies
High blood sugar is a growing concern, often linked to lifestyle, diet, and genetics. Because it can develop without clear symptoms, regular monitoring and healthy habits are important.
Miduty’s Berberine HCL 98% combines berberine with kidney bean, bitter melon, gymnema, chromium, and vitamin B12. These ingredients have been studied for their potential to support normal carbohydrate metabolism and help maintain blood glucose within the normal range. Vitamin B12 also contributes to normal energy metabolism and helps reduce tiredness and fatigue.
This supplement is intended for adults as part of a balanced diet and healthy lifestyle. For personalised advice, consult a healthcare professional.
Scientific/Clinical Studies
[1] https://www.ncbi.nlm.nih.gov/pmc/articles/PMC4027280/
[2] https://www.ncbi.nlm.nih.gov/pmc/articles/PMC2410097/
[3] https://pubmed.ncbi.nlm.nih.gov/15208835/
[4] https://www.ncbi.nlm.nih.gov/pmc/articles/PMC3649932/
[5] https://www.researchgate.net/publication/308578091_Vitamin_B12_Deficiency_and_Metformin_Use
These statements have not been evaluated by the Food and Drug Administration (FDA). This product is not intended to diagnose, treat, cure, or prevent any disease. Individual results may vary.
What’s Inside?






Blood sugar balance can be influenced by lifestyle factors such as diet, activity, and overall health. Eating patterns that include balanced proportions of protein, healthy fats, and carbohydrates, alongside a consistent routine, are often recommended as part of maintaining general wellbeing.
Some research has explored the relationship between long-term use of certain blood sugar–related medicines and vitamin B12 levels, suggesting a possible link to reduced absorption. Vitamin B12 is an essential nutrient that contributes to energy metabolism and normal nervous system function.
Early changes in blood sugar regulation may not always present clear signs. Regular monitoring and professional guidance are important in identifying and managing individual risk factors.
Weight changes can sometimes be associated with how the body uses and stores energy. Insulin, a hormone involved in blood sugar regulation, plays a role in directing glucose into muscles, the liver, and fat cells.
For personalised advice on diet, supplements, or blood sugar management, it is important to consult a qualified healthcare professional.
-
Ingredients
-
Unknown Facts
-
FAQs
What’s Inside?






Blood sugar balance can be influenced by lifestyle factors such as diet, activity, and overall health. Eating patterns that include balanced proportions of protein, healthy fats, and carbohydrates, alongside a consistent routine, are often recommended as part of maintaining general wellbeing.
Some research has explored the relationship between long-term use of certain blood sugar–related medicines and vitamin B12 levels, suggesting a possible link to reduced absorption. Vitamin B12 is an essential nutrient that contributes to energy metabolism and normal nervous system function.
Early changes in blood sugar regulation may not always present clear signs. Regular monitoring and professional guidance are important in identifying and managing individual risk factors.
Weight changes can sometimes be associated with how the body uses and stores energy. Insulin, a hormone involved in blood sugar regulation, plays a role in directing glucose into muscles, the liver, and fat cells.
For personalised advice on diet, supplements, or blood sugar management, it is important to consult a qualified healthcare professional.
PALAK NOTES IS NOW MIDUTY
New Era! Continued Dedication!
Pain that went untreated gave rise to the brand Palak Notes. Pre-COVID, we began to evolve, and over the past three years (and counting), we have dedicated our entire self to learning about the pain and health issues that society suffers. We had a modest beginning, but today we have a large family.
So, in order to adapt to these changes over time, we have decided to create a new brand identity that reflects our team and potential customers. We are now known as MIDUTY. Our vision for the current era is presented and projected through this new identity.
The red pills are now massive capsules that have a weird after taste
Best product ever